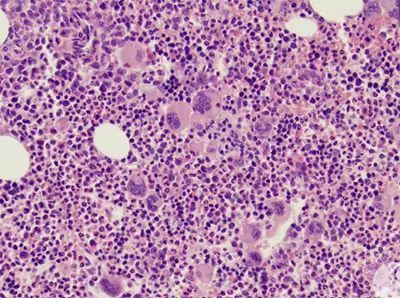
血栓増加症の原因は何ですか?

血小板増加症とは何ですか?
血小板増加症は、自然に存在する血液凝固タンパク質または凝固因子の不均衡が生じている状態です。これにより、血栓が発生するリスクが生じる可能性があります。
血液の凝固、つまり凝固は一般に良いことです。血管が傷ついたときに出血を止める働きがあります。
しかし、血栓が溶けなかったり、怪我をしていなくても血栓が発生しやすい場合は、生命を脅かす深刻な問題になる可能性があります。
血栓は壊れて血流を通って移動する可能性があります。血栓増加症の人は、深部静脈血栓症 (DVT)または肺塞栓症を発症するリスクが高まる可能性があります。血栓は心臓発作や脳卒中を引き起こす可能性もあります。
血栓が発生しない限り症状が現れないため、どれだけの人が血栓増加症を患っているかを言うことは困難です。血小板増加症は遺伝することもあれば、後年に発症することもあります。

血小板増加症の症状は何ですか?
血栓増加症は症状を引き起こさないため、血栓がなければ自分が血栓症であることに気づかないこともあります。血栓の症状は、血栓が存在する場所によって異なります。
- 腕または脚:圧痛、熱さ、腫れ、痛み
- 腹部:嘔吐、下痢、激しい腹痛
- 心臓:息切れ、吐き気、ふらつき、発汗、上半身の不快感、胸の痛みと圧迫感
- 肺:息切れ、発汗、発熱、喀血、心拍数の上昇、胸痛
- 脳:話すのが難しい、視力の問題、めまい、顔や手足の脱力感、突然の激しい頭痛
DVT は通常、片足のみを伴います。症状には次のようなものがあります。
- ふくらはぎや脚の腫れや圧痛
- 足の痛みまたは痛み
- 足を上に曲げると痛みが強くなる
- そのエリアを触ると暖かいです
- 皮膚が赤くなり、通常は脚の後ろ、膝の下が赤くなります。
DVT は両脚に発生することがあります。目、脳、肝臓、腎臓でも発生する可能性があります。
血栓が剥がれて血流に入ると、最終的に肺に到達する可能性があります。そこで肺への血液供給が遮断され、すぐに肺塞栓症と呼ばれる生命を脅かす状態になる可能性があります。
肺塞栓症の症状には次のようなものがあります。
- 胸痛
- 息切れ
- 立ちくらみ、めまい
- 乾いた咳、または血液や粘液を吐き出す咳
- 背中上部の痛み
- 失神
肺塞栓症には緊急治療が必要です。これらの症状がある場合は、すぐに 911 に電話してください。
流産を繰り返す場合は、血栓増加症の可能性がある兆候である可能性もあります。
血栓増加症の原因は何ですか?
血小板増加症にはかなりの種類があり、生まれつきのものと、後になって発症するものがあります。
遺伝子型
第 V 因子ライデン血小板増加症は最も一般的な遺伝型であり、主にヨーロッパ系の人々が罹患します。 F5遺伝子の変異です。
リスクは高まりますが、この遺伝子変異があるからといって、必ずしも血栓の問題が発生するわけではありません。実際、第 V 因子ライデンを持っている人はわずか約 10 パーセントです。
2 番目に一般的な遺伝型はプロトロンビン血小板増加症で、主にヨーロッパ系の人々が罹患します。これには F2 遺伝子の変異が関係します。
遺伝的タイプの血小板増加症は複数の流産のリスクを高める可能性がありますが、これらの遺伝子変異を持つ女性のほとんどは正常に妊娠しています。
その他の継承された形式には次のものがあります。
- 先天性フィブリノゲン異常症
- 遺伝性アンチトロンビン欠乏症
- ヘテロ接合性プロテインC欠損症
- ヘテロ接合性プロテインS欠損症
獲得型
最も一般的な後天性タイプは抗リン脂質症候群です。影響を受ける人の約70パーセントは女性です。また、全身性エリテマトーデス患者の 10 ~ 15 パーセントは抗リン脂質症候群も患っています。
これは、血液を適切な濃度に保つのに役立つリン脂質を抗体が攻撃する自己免疫疾患です。
抗リン脂質症候群は、次のような妊娠合併症のリスクを高める可能性があります。
後天性血小板増加症のその他の原因には次のものがあります。
- 病気中や入院後などの長期の床上安静
- 癌
- 外傷性損傷
- 後天性フィブリノゲン異常症
血小板増加症の有無にかかわらず、血栓発生の危険因子は他にも多数あります。その一部は次のとおりです。
- 肥満
- 手術
- 喫煙
- 妊娠
- 経口避妊薬の使用
- ホルモン補充療法

血小板増加症はどのように診断されますか?
血小板増加症は血液検査によって診断されます。これらの検査では状態を特定できますが、必ずしも原因を特定できるわけではありません。
あなたまたはあなたの家族の誰かが血小板増加症を患っている場合、遺伝子検査によって同じ症状を持つ他の家族を特定できる可能性があります。遺伝子検査を検討する場合は、その結果が治療の決定に影響を与えるかどうかを医師に尋ねる必要があります。
血小板増加症の遺伝子検査は、資格のある遺伝カウンセラーの指導の下でのみ行う必要があります。
血栓増加症の治療選択肢にはどのようなものがありますか?
血栓が発生している場合、または血栓が発生するリスクが高い場合を除き、治療はまったく必要ない場合があります。治療の決定に影響を与える可能性のあるいくつかの要因は次のとおりです。
- 年
- 家族歴
- 全体的な健康状態
- ライフスタイル
血栓が発生するリスクを下げるためにできることがいくつかあります。
- 喫煙する場合はやめてください。
- 健康的な体重を維持してください。
- 定期的に運動しましょう。
- 健康的な食生活を維持してください。
- 長時間の非活動状態や床上安静は避けるようにしてください。
薬剤には、ワルファリンやヘパリンなどの抗凝固剤が含まれる場合があります。ワルファリン(クマディンまたはジャントーベン)は経口薬ですが、効果が現れるまでに数日かかります。早急な治療が必要な血栓がある場合は、ワルファリンと併用できる即効性の注射薬であるヘパリンを使用します。
適切な量のワルファリンを服用していることを確認するには、定期的な血液検査が必要です。血液検査には、プロトロンビン時間検査と国際正規化比 (INR) が含まれます。
用量が低すぎる場合でも、血栓ができるリスクがあります。用量が多すぎると、過剰な出血の危険があります。この検査は、医師が必要に応じて用量を調整するのに役立ちます。
血小板増加症がある場合、または抗凝固薬を服用している場合は、医療処置を受ける前に必ずすべての医療従事者に知らせてください。

血小板増加症の見通しはどのようなものですか?
遺伝性血小板増加症を防ぐことはできません。後天性血小板増加症を完全に防ぐことはできませんが、血栓が発生する可能性を減らすために実行できる手順がいくつかあります。
血栓は直ちに治療する必要があるため、警告サインを理解してください。
血栓増加症であっても、血栓が発生しない、または治療が必要ない場合もあります。場合によっては、医師が抗凝血剤の長期使用を推奨する場合があり、その場合は定期的な血液検査が必要になります。
血小板増加症はうまく管理できます。
参考文献
- https://ghr.nlm.nih.gov/condition/prothrombin-thrombophilia#statistics
- https://bjgp.org/content/64/619/e120
- https://www.nhs.uk/conditions/thrombophilia/
- https://ghr.nlm.nih.gov/condition/antiphospholipid-syndrome#statistics
- https://ghr.nlm.nih.gov/condition/factor-v-leiden-thrombophilia#Heading
- https://ghr.nlm.nih.gov/condition/factor-v-leiden-thrombophilia#statistics
血小板増加症についてのすべて・関連動画
免責事項: 健康百科事典ブログは、すべての情報が事実に基づき、包括的で最新のものであるよう努めています。しかし、この記事は、資格を持つ医療専門家の知識や専門性の代替として使用されるべきではありません。薬を服用する前には、必ず医師または他の医療専門家に相談してください。ここに記載されている情報は変更される可能性があり、すべての可能な用途、指示、注意事項、警告、薬物相互作用、アレルギー反応、副作用を網羅することを意図しているわけではありません。特定の薬物または薬物の組み合わせに関する警告や情報が記載されていない場合でも、その薬物や組み合わせがすべての患者やすべての用途において安全、有効、適切であることを意味するものではありません。
